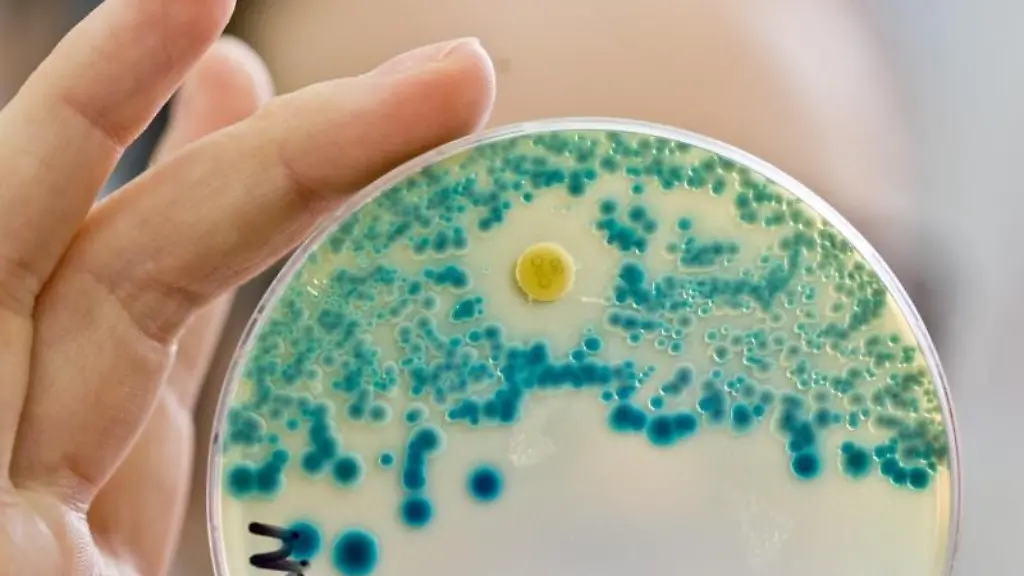
Nachweis-von-resistenten-Bakterien-Die-Europaeische-Arzneimittel-Agentur-EMA-fordert-die-Verwendung-des-Antibiotikums-Colistin-bei-Tieren-drastisch-einzuschraenken

Forscher: "Für uns überraschend"Klinikpatienten bringen gefährliche Keime mit
In Deutschland sterben bis zu 15.000, vielleicht sogar 30.000 Patienten im Jahr an Krankenhausinfektionen. Eine große Rolle spielen hier die multiresistenten Bakterien, denen die gängigen Antibiotika nichts mehr anhaben können. Doch wo kommen diese Keime her?
Fast jeder zehnte Krankenhauspatient bringt gefährliche multiresistente Keime mit in die Klinik. Von mehr als 4300 untersuchten Patienten an mehreren deutschen Universitätskliniken waren 416 bei der Aufnahme mit multiresistenten Darmbakterien besiedelt, wie das Deutsche Zentrum für Infektionsforschung (DZIF) in Braunschweig mitteilte. Diese Häufigkeit war bisher in Deutschland nicht bekannt.
Besonders oft fanden die Wissenschaftler demnach Escherichia-coli-Bakterien, sogenannte ESBL-Enterobakterien. Diese Keime gehören zur normalen menschlichen Darmflora, für Kranke und Schwache sind sie aber eine Gefahr. Sie können Infektionen in anderen Organen hervorrufen wie zum Beispiel eine Harnwegsinfektion. Eine durch multiresistente Bakterien hervorgerufene Infektion ist sehr viel schwieriger zu therapieren, weil viele Antibiotika nicht mehr anschlagen.
Zunehmendes Problem in Krankenhäusern
Multiresistente Erreger sind seit Jahren ein zunehmendes Problem vor allem in Krankenhäusern. Nach offiziellen Schätzungen erkranken jährlich 400.000 bis 600.000 Patienten an Krankenhausinfektionen. 10.000 bis 15.000 sterben jedes Jahr daran.
Die Deutsche Gesellschaft für Krankenhaushygiene (DGKH) geht sogar von fast einer Million Infektionen und mindestens 30.000 Todesfällen aus. Meistens handelt es sich um den Methillicin-resistenten Staphylococcus aureus - kurz MRSA. Dieser Bakterienstamm kann schwere bis tödliche Infektionen verursachen.
Die Forscher haben nun an sechs Unikliniken Patienten auf multiresistente Darmkeime untersucht. "Dass fast jeder zehnte Patient mit multiresistenten Keimen besiedelt ist, wenn er in der Klinik ankommt, war für uns überraschend", erklärte Axel Hamprecht von der Uniklinik Köln, die die Studie gemeinsam mit der Berliner Charité koordinierte.
Weltweite Ausbreitung
Die multiresistenten Darmbakterien, die unter anderem gegen Cephalosporine resistent sind, haben sich in den vergangenen Jahren weltweit ausgebreitet. Cephalosporine sind Antibiotika, die ähnlich wie das Penicillin den Aufbau der bakteriellen Zellwand hemmen und die Bakterien auf diese Weise töten.
Die neueren Cephalosporine der dritten Generation wirken gegen ein breites Spektrum an Bakterien und gehören zu den am häufigsten eingesetzten Antibiotika. Doch die Bakterien setzen sich zur Wehr und haben im Laufe der Zeit ein Enzym erworben, das diese Antibiotika unwirksam macht.
Von Klinik zu Klinik unterschiedlich
Die Häufigkeit der multiresistenten Keime war demnach von Klinik zu Klinik unterschiedlich. Es zeigte sich jedoch, dass Patienten nach der Einnahme von Antibiotika und Reisende außerhalb Europas gefährdeter sind.
Bakterien sind sehr anpassungsfähig. Durch Veränderungen im Erbgut können die Erreger unempfindlich gegenüber bestimmten Antibiotika werden. Der übermäßige Einsatz von Antibiotika beim Menschen und in der Tiermast sowie eine unsachgemäße Einnahme der Medikamente fördert solche Resistenzbildungen.